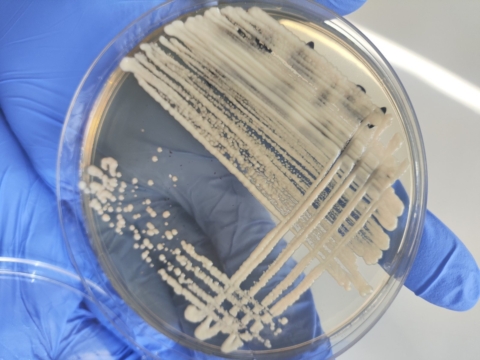

12 березня 2026 року за сприяння генерального директора Запорізького обласного центру контролю та профілактики хвороб Тараса Тищенка та заступника генерального директора з впровадження системи управління якістю лабораторних досліджень Ольги Гаврікової відповідно до плану проведення тренінгів, у бактеріологічній лабораторії проведено черговий захід із відпрацювання практичних навичок за такими розділами:
-прийом зразків біологічного матеріалу для дослідження;
– дослідження біологічного матеріалу на наявність грибів (дріжджових, дріжджоподібних та міцеліальних);
-бактеріологічні дослідження ефективності роботи парових стерилізаторів.
Також на тренінгу була присутня менеджер з якості Медичної лабораторії Віра Яковенко. Фахівці оновили знання за заявленими тематиками та успішно підтвердили свою компетентність у зазначених напрямах роботи.
Чому такі заходи є важливими для нашої Установи:
1. Підтвердження технічної компетентності персоналу Згідно з розділом «Персонал» стандарту ISO 15189, лабораторія повинна постійно підтримувати та оцінювати навички співробітників. Робота з міцеліальними грибами або перевірка стерилізаторів вимагає високої точності. Тренінги гарантують, що кожен фахівець виконує маніпуляції однаково правильно, мінімізуючи ризик помилок.
2. Забезпечення якості преаналітичного етапу Якість результату на 60-70% залежить від етапу прийому та ідентифікації біоматеріалу. Стандарт ISO 15189 вимагає суворого контролю саме «на вході», щоб уникнути втрати сенсу подальших досліджень.
3. Управління ризиками та безпека Контроль роботи парових стерилізаторів — це фундамент біологічної безпеки. Регулярне оновлення навичок дозволяє лабораторії впевнено гарантувати стерильність процесів та уникнути контамінації.
4. Роль менеджменту та безперервне вдосконалення Участь керівництва та менеджерів з якості підкреслює принцип лідерства (Leadership), який є ключовим для стабільного розвитку системи управління якістю.